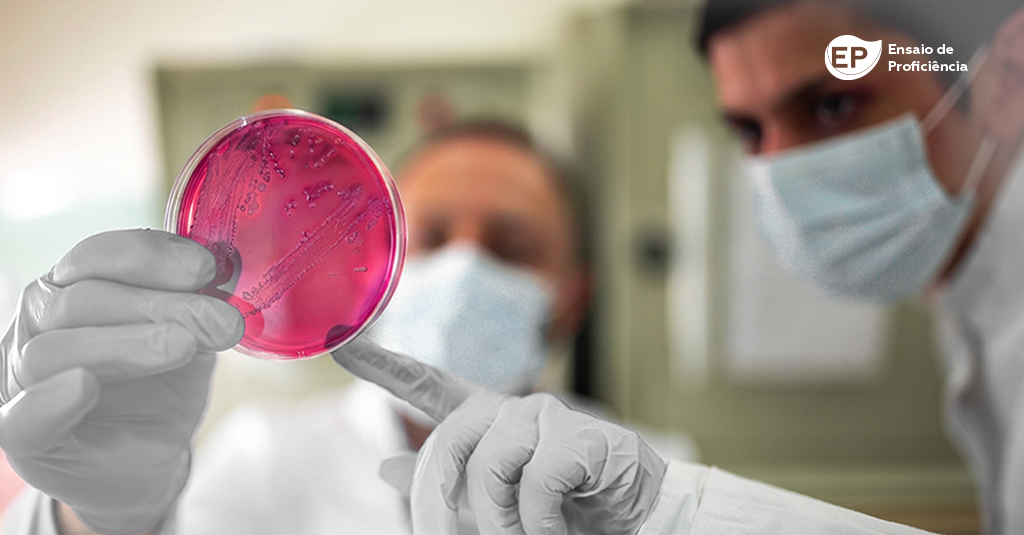

Enquete realizada durante o mês de julho coleta as consequências da pandemia de COVID-19 do ponto de vista da gestão laboratorial e as informações serão fonte de valioso aprendizado para o setor
O comitê de gestão da Sociedade Brasileira de Patologia Clínica/Medicina Laboratorial (SBPC/ML), em conjunto com a Controllab, pretende conhecer a realidade dos laboratórios durante a pandemia, do ponto de vista da gestão laboratorial.
Em um período crítico como este, pelo qual o mundo passa com a pandemia de COVID-19, os laboratórios clínicos são fundamentais para diagnóstico, isolamento de pacientes contaminados, tratamento e monitoramento desses pacientes durante e após suas internações.
As consequências deste período para a gestão laboratorial foram inúmeras. Assim, o que se pretende com esta enquete é documentar este período, aprender com os acertos e soluções inovadoras criadas e elaborar sugestões de como foram superadas as maiores dificuldades vivenciadas.
Com o apoio de especialistas, foi elaborado um questionário que contempla diferentes tópicos relacionados ao tema de gestão na pandemia. Os tópicos estão listados no sumário da enquete.
A Controllab, parceira da SBPC/ML, atua como uma empresa imparcial, auxiliando na prospecção da enquete junto a Sociedade e em compilar as informações finais obtidas, conforme sua política de privacidade adotada.
Para participar, o laboratório deve atuar no segmento clínico e eleger um representante responsável por responder o questionário, a fim de evitar múltiplas respostas de uma mesma organização.
A enquete está disponível para contribuições durante o mês de julho/21 e os resultados estão previstos para divulgação ainda no segundo semestre deste ano.
Contribua nesta iniciativa que documentará um momento marcante da vida da Patologia Clínica e servirá para análises mais aprofundadas posteriormente.
Para responder, acesse o link da pesquisa.